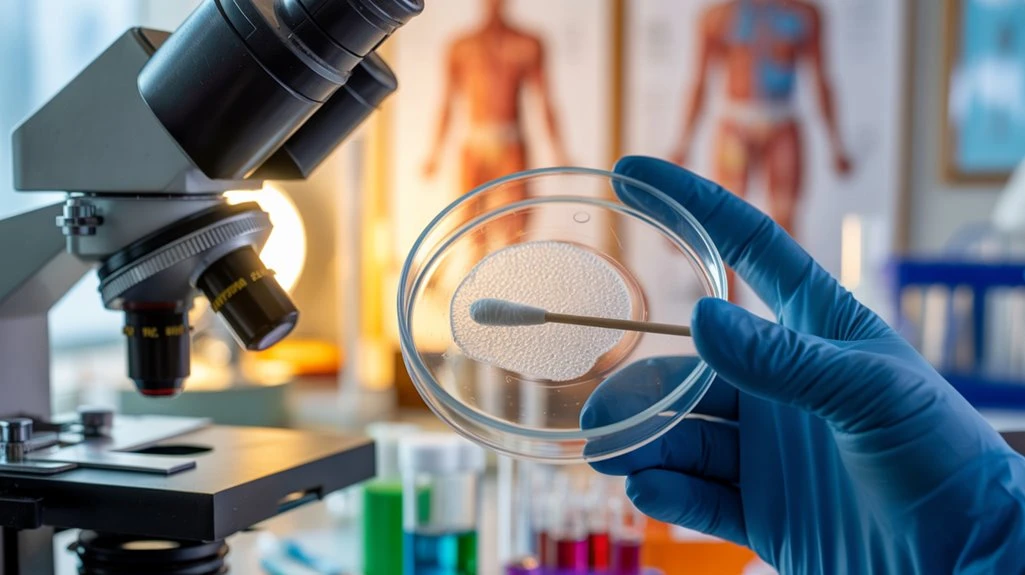

Blog

by Lily Yang | Sep 18, 2025 | dry eye disease, dry eye in blepharitis, dry eye pain, dry eye relief, dry eye symptoms, dry eye syndrome, Dry Eye Syndrome Causes, Dry Eye Syndrome Insights, dry eye treatment, dry eyelids, dry eyes, dry eyes at night, Dry Eyes Diagnosis Methods
Curious about which supplements really soothe dry eyes? Check out the top 10 expert-backed choices that could transform your eye comfort today.

by Lily Yang | Sep 17, 2025 | watery and crusty eyes, watery crusty eyes, watery eyes, watery eyes treatments
Often overlooked, watery discharge can reveal surprising clues about your health—discover what your body might be trying to tell you next.

by Lily Yang | Sep 16, 2025 | chalazia, chalazion, Chalazion and Blepharitis Causes, chalazion and MGD, Chalazion and Tear Production, Chalazion Blurred Vision Symptoms, chalazion management, Chalazion Pain and Discomfort, chalazion surgery, Chalazion Treatment Options, chalazion treatments, chalazions
If you’re wondering whether a hardened chalazion will disappear on its own, discover what really happens when it refuses to budge.

by Lily Yang | Sep 15, 2025 | watering eyes, watery and crusty eyes, watery crusty eyes, watery eyes, watery eyes treatments
Keep your mornings dry and comfortable by uncovering expert steps to stop watery eyes—discover what might be causing your symptoms next.

by Lily Yang | Sep 12, 2025 | red crusty eyes, watery crusty eyes
If your eyes are red and crusty, it could signal something more serious than simple irritation—discover the hidden causes that might surprise you.

by Lily Yang | Sep 11, 2025 | Dry Eye Blinking Exercises, dry eye disease, dry eye in blepharitis, dry eye pain, dry eye relief, dry eye symptoms, dry eye syndrome, Dry Eye Syndrome Causes, Dry Eye Syndrome Insights, dry eye treatment, dry eyes
What really happens if dry eye is left untreated may surprise you—discover the hidden risks before it’s too late.

by Lily Yang | Sep 10, 2025 | Ocular Rosacea, ocular rosacea diagnosis, ocular rosacea treatment
Meet the top 7 eye drops for ocular rosacea in 2025—discover which formula could finally soothe your symptoms and why one might surprise you.

by Lily Yang | Sep 9, 2025 | chalazia, chalazion, chalazion and MGD, Chalazion and Tear Production, Chalazion Blurred Vision Symptoms, chalazion management, Chalazion Pain and Discomfort, Chalazion Prescription Drops, chalazion surgery, Chalazion Treatment Options, chalazion treatments, chalazions
Want to know how to get rid of a chalazion fast? Discover five expert-backed steps that could clear your eyelid sooner than you think.

by Lily Yang | Sep 8, 2025 | Crusting in Eyes, crusty eyelashes, crusty eyelids, crusty eyes, morning eye crust
The real reason your eyes are so crusty in the morning might surprise you—discover what your symptoms could be saying about your eye health.

by Lily Yang | Sep 5, 2025 | chalazia, chalazion, Chalazion and Blepharitis Causes, chalazion and MGD, Chalazion and Tear Production, Chalazion Blurred Vision Symptoms, chalazion management, Chalazion Pain and Discomfort, Chalazion Prescription Drops, chalazions
Wondering what happens as a chalazion heals? Discover the key stages and what to expect next as you follow your recovery journey.